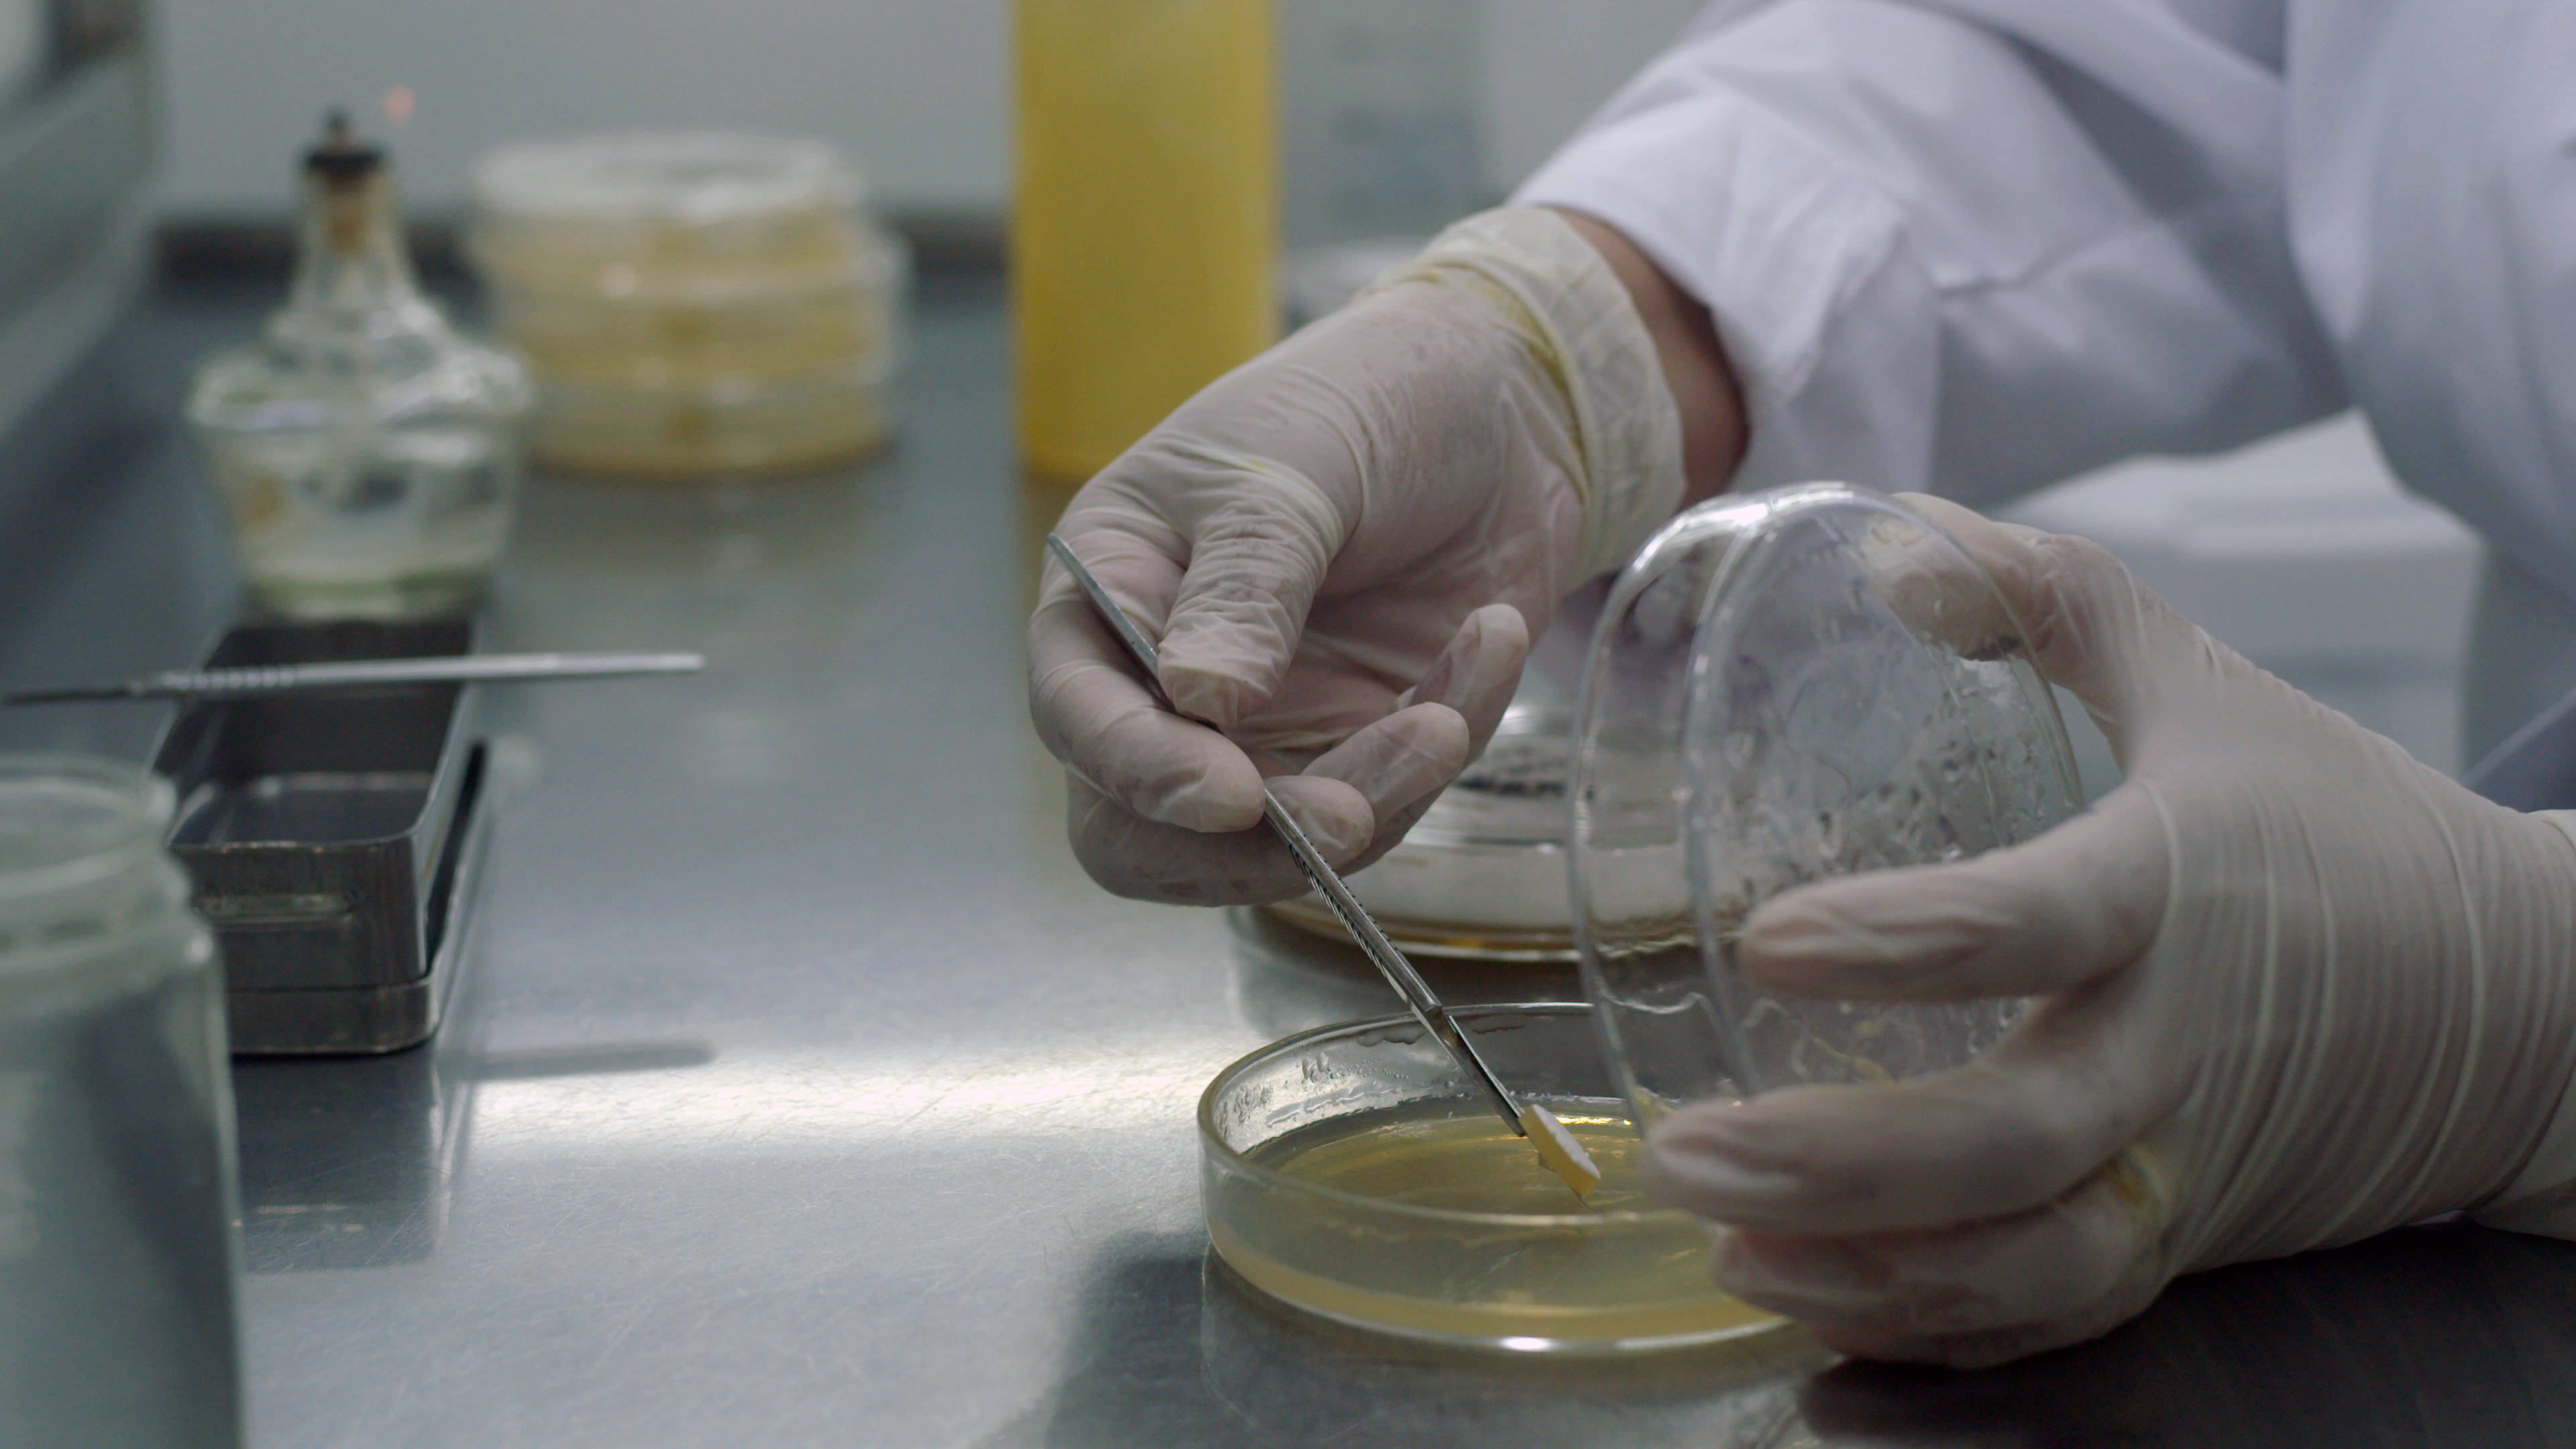

ORIGENA : UN FUTURO BIOMATERIAL, Realizado en el Marco del Programa Nacional RENACER AUDIOVISUAL del Ministerio de Cultura, Para Canal Encuentro, a estrenarse este Viernes 25 a las 20 HS. Origena Un Futuro Biomaterial.
de @origena.lab con @agustinaruiz.studio y @vicminguez
Documental Realizado en el Marco de Unitarios Federales de Renacer Audiovisual. Para el Ministerio de Cultura. Pueden encontrarlo en Plataforma @somoscontar o @canalencuentro
Producción @alejocastro21 - Asist. Producción @yesantivecchi - Dirección @flowdelmal - Asist Dirección @imibleu -Edición @sebalynch_ - DF @agussfa_ - Foquista @rodrigopicoestrada - Eléctrico @lautaroprieto22 - Sonido Directo y Post Facundo Carelli - Dir Arte @poli.pxl - Asist Arte @aniubal - Make up @karyannmakeup
de @origena.lab con @agustinaruiz.studio y @vicminguez
Documental Realizado en el Marco de Unitarios Federales de Renacer Audiovisual. Para el Ministerio de Cultura. Pueden encontrarlo en Plataforma @somoscontar o @canalencuentro
Producción @alejocastro21 - Asist. Producción @yesantivecchi - Dirección @flowdelmal - Asist Dirección @imibleu -Edición @sebalynch_ - DF @agussfa_ - Foquista @rodrigopicoestrada - Eléctrico @lautaroprieto22 - Sonido Directo y Post Facundo Carelli - Dir Arte @poli.pxl - Asist Arte @aniubal - Make up @karyannmakeup